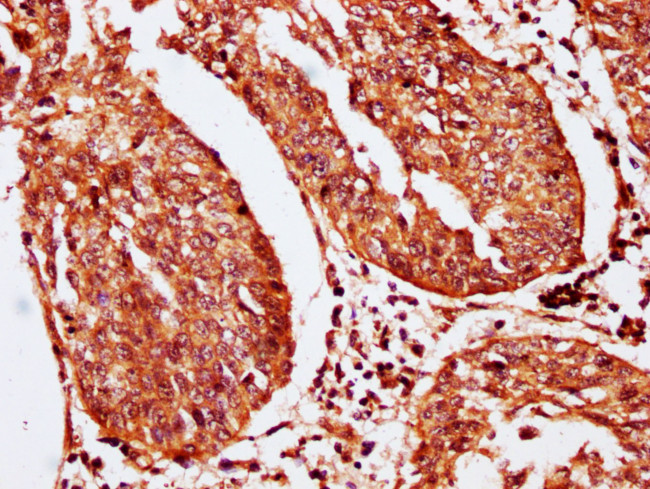
SERPINB2 Antibody in Immunohistochemistry (Paraffin) (IHC (P))

Search
Invitrogen
SERPINB2 Polyclonal Antibody
{{$productOrderCtrl.translations['antibody.pdp.commerceCard.promotion.promotions']}}
{{$productOrderCtrl.translations['antibody.pdp.commerceCard.promotion.viewpromo']}}
{{$productOrderCtrl.translations['antibody.pdp.commerceCard.promotion.promocode']}}: {{promo.promoCode}} {{promo.promoTitle}} {{promo.promoDescription}}. {{$productOrderCtrl.translations['antibody.pdp.commerceCard.promotion.learnmore']}}
图: 1 / 2
SERPINB2 Antibody (PA5-98140) in IHC (P)


Please note: We are reviewing Western blot images included in the antibody testing data in our catalog, including those provided by third parties. Unless expressly labeled or annotated as “raw-unedited”, Western blot images included in the antibody testing data in our catalog may have been edited, optimized or otherwise adjusted for presentation.
产品信息
PA5-98140
种属反应
宿主/亚型
分类
类型
抗原
偶联物
形式
浓度
规格
纯化类型
保存液
内含物
保存条件
运输条件
RRID
靶标信息
PAI-2 is an inhibitory serpin expressed mainly in keratinocytes, activated monocytes, and placental trophoblasts. It exists predominantly as a 47 kDa, nonglycosylated, intracellular protein, which can be induced to be secreted as 60 kDa glycoprotein. The glycosylated and unglycosylated forms of PAI-2 are equally effective as inhibitors of urokinase-type plasminogen activator (uPA), the only established physiological target of this serpin. PAI-2 has a unique ability to form dormant polymers spontaneously and reversibly under physiological conditions. The physiological relevance of this property, which is neither a consequence of any mutation in the PAI-2 gene nor associated with any known disorder, is still unclear. However, it appears that the formation of intracellular, dormant polymers may be important for the controlled release of the inhibitor from PAI-2 producing cells. Plasma levels of PAI-2 are usually low or undetectable, except during pregnancy and in some forms of monocytic leukemia. Secretion of PAI-2 from the placenta normally occurs during the third trimester of pregnancy, and accounts for the dramatic increase in PAI-2 levels (up to 250 ng/ml), which are maintained at these levels until postpartum, and then rapidly decline. In addition to its vital role in protecting the placenta from degradation by uPA and/or uPA-activated proteases, PAI-2 has been shown to be essential for the prevention of metastatic spread of neck, lung and breast cancers. The beneficial effect of PAI-2 seen in these studies is presumed to stem from its ability to inhibit uPA-dependent cell dissemination. PAI-2 has also been reported to inhibit keratinocyte proliferation, and to participate in the innate immune response during viral infection.
仅用于科研。不用于诊断过程。未经明确授权不得转售。
篇参考文献 (0)
生物信息学
蛋白别名: Monocyte Arg-serpin; PAI-2; Placental plasminogen activator inhibitor; plasminogen activator inhibitor; Plasminogen activator inhibitor 2; plasminogen activator inhibitor precursor; plasminogen activator inhibitor type 2 precursor; plasminogen activator inhibitor, type II (arginine-serpin); plasminogen-activator inhibitor; serine (or cysteine) proteinase inhibitor, clade B (ovalbumin), member 2; Serpin B2; serpin peptidase inhibitor, clade B (ovalbumin), member 2; unnamed protein product; Urokinase inhibitor
基因别名: HsT1201; PAI; PAI-2; PAI2; PLANH2; SERPINB2
Entrez Gene ID: (Human) 5055